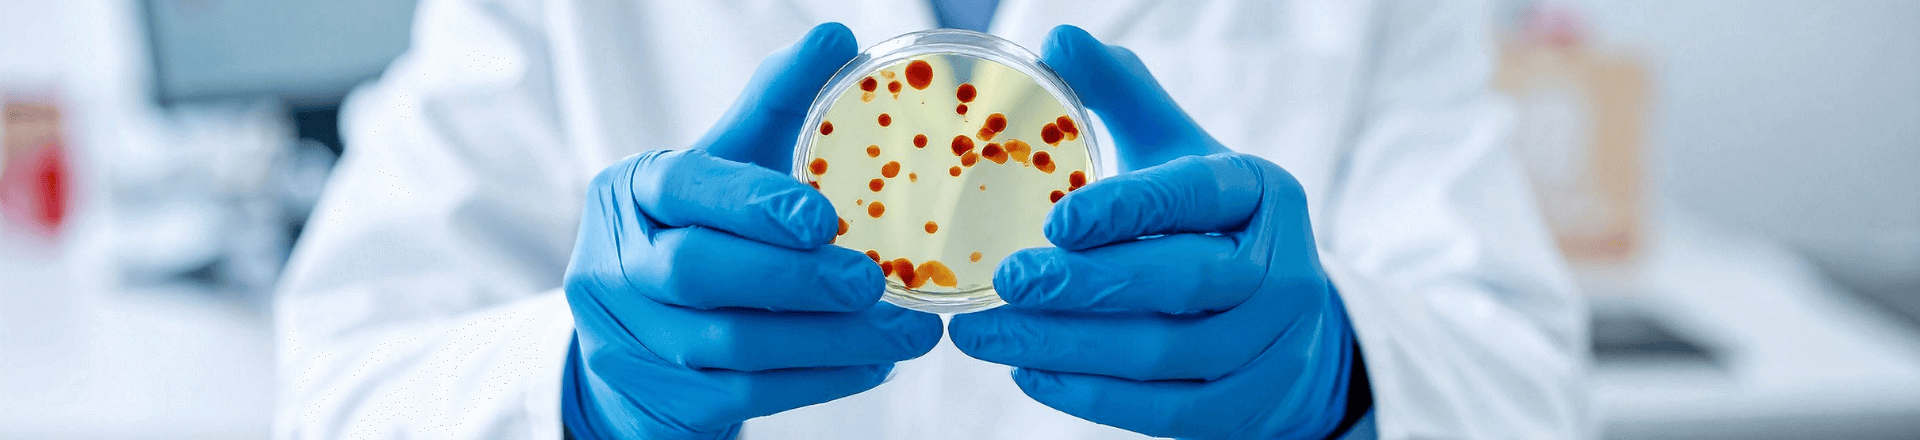
alt description

Orthopedie
Deze pagina is dé plek waar je betrouwbare en begrijpelijke informatie vindt over botten, gewrichten en beweging bij huisdieren. Hier lees je hoe orthopedische problemen worden herkend en behandeld.
Onze dierenartsen delen hun kennis in overzichtelijke artikels, gebundeld per thema. Zo vind je snel antwoorden op jouw vragen en kan je eenvoudig doorklikken naar onderwerpen die je interesseren.




Gewrichten
Gewrichtsaandoeningen bij huisdieren kunnen pijn, stijfheid en bewegingsproblemen veroorzaken. In dit onderdeel lees je hoe dierenartsen deze aandoeningen herkennen, welke behandelingen beschikbaar zijn en hoe je de mobiliteit van je dier zo goed mogelijk kan ondersteunen.
De schouder kan bij huisdieren getroffen worden door verschillende aandoeningen zoals OCD, instabiliteit of een bicepspeesletsel. Ook afwijkingen zoals dysplasie, elleboogincongruentie of letsels die een reconstructie of bicepstranspositie vereisen, komen voor.
Elleboogaandoeningen zoals FPC, mediale compartmentsyndroom, LPA en LPC zijn veelvoorkomende oorzaken van kreupelheid. Ook dysplasie en incongruentie kunnen pijn en bewegingsproblemen veroorzaken.
Bij de pols (carpus) zijn instabiliteitsproblemen de meest voorkomende orthopedische aandoening. In dit onderdeel lees je hoe instabiliteit wordt opgespoord, welke klachten het veroorzaakt en welke chirurgische of conservatieve behandelingen mogelijk zijn.
De heup kan getroffen worden door aandoeningen zoals heupdysplasie, heupluxatie of artrose. Behandelingen variëren van heupkopresectie tot meer geavanceerde technieken zoals DPO/TPO, heupprothesen of JPS.
Knieproblemen komen vaak voor bij honden en katten. Bekende aandoeningen zijn gescheurde kruisbanden (behandeld met technieken zoals TPLO, TTA of CBLO) en patellaluxatie.
De hak of tarsus kan aangetast worden door aandoeningen zoals OCD, instabiliteit of ernstige letsels waarvoor een pantarsale of tarsometatarsale artrodese nodig is.
Artrose of gewrichtsslijtage is een veelvoorkomende aandoening bij oudere dieren, maar kan ook op jongere leeftijd ontstaan na letsels of andere gewrichtsproblemen. Hier lees je hoe artrose wordt herkend, welke behandelingen verlichting bieden en hoe je je dier kan ondersteunen in het dagelijks leven.


Spier- en peesaandoeningen
Spier- en peesproblemen uiten zich vaak in kreupelheid of verminderde kracht. Hier vind je uitleg over de meest voorkomende aandoeningen, de manier waarop ze worden gediagnosticeerd en welke therapieën bijdragen aan herstel.
Een gescheurde pees kan leiden tot acute pijn en duidelijke kreupelheid. Afhankelijk van de ernst wordt gekozen voor chirurgische herstelling of conservatieve behandeling. Hier lees je hoe peesrupturen worden opgespoord en behandeld.
Ontstekingen en overbelastingsletsels van pezen zoals de bicepspees en flexor-entheseopathieën komen vaak voor. In dit onderdeel ontdek je hoe deze aandoeningen worden herkend, welke klachten ze veroorzaken en welke behandelingsopties bestaan.
Plotselinge overbelasting kan leiden tot scheuren in spierweefsel. Deze tekst licht toe hoe spierscheuren ontstaan, welke symptomen erop wijzen en welke therapieën helpen bij herstel.
Bij spierziekten zoals masticatoire myositis, gegeneraliseerde myositis of spierdegeneratie is vaak een uitgebreid onderzoek nodig. Hier lees je hoe deze aandoeningen worden opgespoord en welke mogelijkheden er zijn om spiermassa en functionaliteit te behouden.


Fracturen
Breuken of scheuren in botten vereisen een snelle en gerichte aanpak. Op deze pagina lees je hoe fracturen worden vastgesteld, welke behandelingsopties er bestaan en hoe het hersteltraject bij dieren wordt ondersteund.
Traumatische fracturen, zoals open of gesloten botbreuken, vereisen een snelle diagnose en behandeling. Behandelingen variëren van chirurgische ingrepen zoals osteosynthese tot conservatieve technieken. Deze tekst geeft een overzicht van de mogelijkheden.
Niet alle botbreuken zijn het gevolg van trauma. Pathologische fracturen kunnen ontstaan door tumoren, metabole afwijkingen of infecties. Hier lees je hoe dierenartsen dit onderscheiden en welke behandelopties er bestaan.


Groei- & ontwikkelingsstoornissen
Bij jonge dieren kunnen groeiproblemen leiden tot blijvende afwijkingen in botten of gewrichten. In dit onderdeel ontdek je hoe zulke stoornissen worden opgespoord, welke behandelingen mogelijk zijn en hoe tijdige zorg complicaties voorkomt.
Bij jonge dieren kunnen afwijkende stand van poten of gewrichten leiden tot blijvende klachten. In dit onderdeel lees je hoe standaafwijkingen worden vastgesteld en welke behandelingsopties (van chirurgie tot conservatieve zorg) beschikbaar zijn.
Verstoringen in calcium- en fosforhuishouding of een vitamine D-tekort kunnen leiden tot ernstige botproblemen tijdens de groei. Hier ontdek je hoe deze aandoeningen ontstaan, hoe ze worden gediagnosticeerd en welke behandelingen verlichting bieden.
Dysplasieën zoals heupdysplasie of elleboogdysplasie behoren tot de meest voorkomende ontwikkelingsstoornissen. Behandelingen lopen uiteen van chirurgische technieken zoals FHO, DPO, JPS en heupprothese tot ingrepen aan schouder of elleboog.
Osteochondritis dissecans (OCD) is een aandoening die bij jonge dieren pijn en kreupelheid veroorzaakt. Hier lees je hoe OCD zich ontwikkelt, hoe het wordt vastgesteld en welke behandelingsmogelijkheden er bestaan.
Panosteïtis is een pijnlijke aandoening van het bot die vaak voorkomt bij jonge, snelgroeiende honden. In dit onderdeel lees je hoe dierenartsen de aandoening opsporen, welke klachten typisch zijn en hoe het herstel verloopt.


Immunologische gewrichtsaandoeningen
Sommige gewrichtsproblemen ontstaan door een verstoring van het immuunsysteem. Hier lees je hoe deze aandoeningen worden herkend, welke onderzoeken nodig zijn en hoe een behandelplan wordt opgesteld om de klachten te beperken.
Polyartritis ontstaat wanneer meerdere gewrichten tegelijk ontstoken raken. Dit kan idiopathisch zijn, waarbij de oorzaak onbekend is, of immuungemedieerd, waarbij het eigen afweersysteem de gewrichten aanvalt. In dit onderdeel lees je hoe dierenartsen de diagnose stellen en welke behandelingen verlichting bieden.
Systemische lupus erythematosus (SLE) is een zeldzame auto-immuunziekte waarbij het immuunsysteem verschillende organen en ook de gewrichten aantast. Hier lees je hoe de aandoening wordt opgespoord en welke mogelijkheden er zijn om klachten onder controle te houden.
Bij immuungemedieerde myositis valt het lichaam het eigen spierweefsel aan, wat leidt tot pijn en verminderde spierkracht. Deze tekst licht toe hoe de ziekte wordt herkend en welke behandelingsstrategieën beschikbaar zijn.

Infectieuze gewrichtsaandoeningen
Bacteriën of andere ziekteverwekkers kunnen leiden tot pijnlijke infecties in gewrichten. Deze tekst licht toe hoe dierenartsen een diagnose stellen, welke behandelingen nodig zijn en wat je kan verwachten tijdens de genezingsfase.
Infecties zoals Ehrlichia, Borrelia (Lyme) en Anaplasma worden via teken overgedragen en kunnen ernstige gewrichtsontstekingen veroorzaken. Hier ontdek je hoe deze ziekten zich uiten, hoe de diagnose wordt gesteld en welke behandelingen worden toegepast.
Sepsis in gewrichten (septische artritis) of een botinfectie zoals osteomyelitis kan grote schade aanrichten. In dit onderdeel lees je hoe deze bacteriële infecties ontstaan, hoe ze opgespoord worden en welke therapieën het herstel ondersteunen.
Mycoplasma is een bacterie die gewrichtsproblemen kan veroorzaken en vaak moeilijk te bestrijden is. Deze tekst geeft inzicht in de symptomen, de diagnostische aanpak en de behandelingsmogelijkheden.
Leishmania is een belangrijke oorzaak van parasitaire gewrichtsproblemen. In dit onderdeel lees je hoe de infectie het lichaam aantast, welke klachten dit geeft en hoe de behandeling verloopt.
Schimmels zoals Aspergillus kunnen leiden tot osteomyelitis, een ernstige botontsteking. Hier ontdek je hoe deze infecties worden vastgesteld en welke therapieën kunnen helpen om de ziekte onder controle te krijgen.


Amputaties
Soms is amputatie de enige optie om pijn te verlichten of een dier een goede levenskwaliteit te bieden. Hier lees je hoe het proces verloopt, wat de revalidatie inhoudt en hoe dieren verrassend goed leren omgaan met deze ingreep.
Soms is amputatie de enige oplossing om een dier pijnvrij en met een goede levenskwaliteit verder te laten leven. Dit kan gaan om het verwijderen van een volledige poot, maar ook om kleinere ingrepen zoals amputaties van tenen, de staart of delen van de kaak. In dit onderdeel lees je hoe een amputatie medisch wordt benaderd, hoe het herstel verloopt en hoe dieren verrassend goed leren omgaan met het verlies van een lichaamsdeel.


Orthopedische hulpmiddelen
Van braces tot rolstoeltjes: orthopedische hulpmiddelen kunnen de mobiliteit van je huisdier aanzienlijk verbeteren. In dit onderdeel ontdek je welke opties er bestaan en hoe dierenartsen de juiste keuze maken voor elk individueel dier.
Braces zoals een carpusbrace of kniebrace worden vaak ingezet om gewrichten te stabiliseren of om herstel na een ingreep te ondersteunen. Hier lees je hoe deze hulpmiddelen werken, in welke situaties ze nuttig zijn en hoe ze bijdragen aan een beter herstel.
Wanneer lopen moeilijker wordt, kunnen hulpmiddelen zoals een loopkarretje, tilharnassen of begeleiding bij traplopen een groot verschil maken. In dit onderdeel lees je welke opties er bestaan en hoe ze op maat van je huisdier worden gekozen.
Revalidatie helpt huisdieren herstellen na een operatie of blessure, en ondersteunt dieren met chronische klachten. Er bestaan verschillende therapieën die ingezet worden afhankelijk van de aandoening. Hydrotherapie helpt spieren versterken en gewrichten soepel houden, lasertherapie ondersteunt pijnbestrijding en wondgenezing, en oefentherapie bevordert een actief herstel.